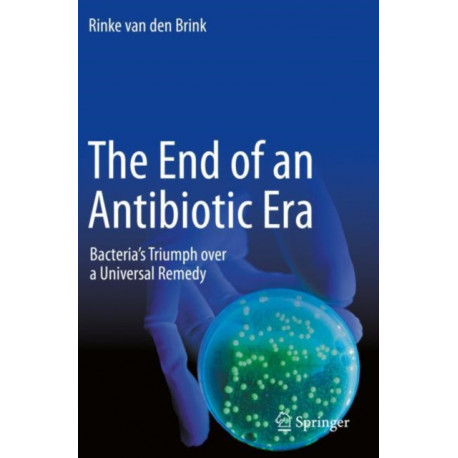

Kurv
Vare
varer
(tom)
Ingen varer
Fastlægges senere
Forsendelse
0,- kr
I alt
The End of an Antibiotic Era: Bacteria's Triumph over a Universal Remedy
(Bog, Paperback / softback, Engelsk)
Forlag:
Springer Nature Switzerland AG
- Type: Bog
- Format: Paperback / softback
-
Sprog:
Engelsk

- ISBN-13: 9783030707224
- Se flere detaljer ▼
Bemærk: Kan leveres før jul.
Beskrivelse
Rinke van den Brink uses the example of a border-spanning collaboration between the Netherlands and Germany to demonstrate how effective lines of communication can be established.The book offers a wealth of useful background information for healthcare personnel.
Læsernes anmeldelser (0)
Alle detaljer
| Forlag | Springer Nature Switzerland AG |
| Forfatter | RINKE VAN DEN BRINK |
| Type | Bog |
| Format | Paperback / softback |
| Sprog | Engelsk |
| Udgave | 2021 ed. |
| Udgivelsesdato | 14-05-2021 |
| Første udgivelsesår | 2021 |
| Illustrationer | 4 Illustrations, black and white; XIX, 322 p. 4 illus. |
| Originalsprog | Switzerland |
| Sideantal | 322 |
| Indbinding | Paperback / softback |
| Forlag | Springer Nature Switzerland AG |
| Sideoplysninger | 322 pages, 4 Illustrations, black and white; XIX, 322 p. 4 illus. |
| Mål | 156 x 234 x 24 |
| ISBN-13 / EAN-13 | 9783030707224 |

